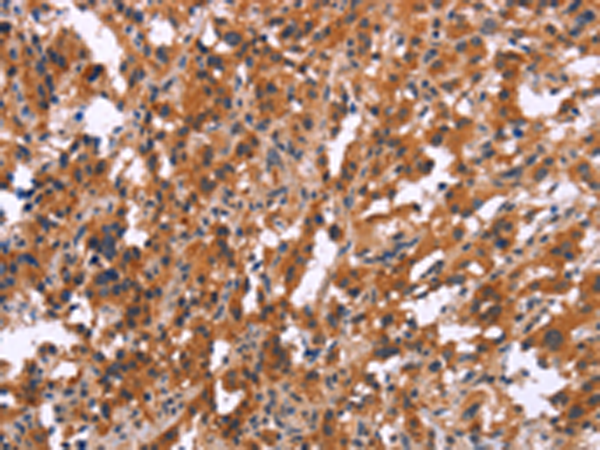
一抗

中文名稱: 兔抗MAPK11 多克隆抗體
英文名稱: Anti-MAPK11 rabbit polyclonal antibody
別 名: P38B; SAPK2; p38-2; PRKM11; SAPK2B; p38Beta; P38BETA2
相關(guān)類別: 一抗
儲 存: 冷凍(-20℃)
宿 主: Rabbit
抗 原: MAPK11
反應(yīng)種屬: Human
標 記 物: Unconjugate
克隆類型: rabbit polyclonal
技術(shù)規(guī)格
|
Background: |
The protein encoded by this gene is a member of the MAP kinase family. MAP kinases act as an integration point for multiple biochemical signals, and are involved in a wide variety of cellular processes such as proliferation, differentiation, transcription regulation, and development. This kinase is most closely related to p38 MAP kinase, both of which can be activated by proinflammatory cytokines and environmental stress. This kinase is activated through its phosphorylation by MAP kinase kinases (MKKs), preferably by MKK6. Transcription factor ATF2/CREB2 has been shown to be a substrate of this kinase. |
|
Applications: |
ELISA, IHC |
|
Name of antibody: |
MAPK11 |
|
Immunogen: |
Synthetic peptide of human MAPK11 |
|
Full name: |
mitogen-activated protein kinase 11 |
|
Synonyms: |
P38B; SAPK2; p38-2; PRKM11; SAPK2B; p38Beta; P38BETA2 |
|
SwissProt: |
Q15759 |
|
ELISA Recommended dilution: |
1000-2000 |
|
IHC positive control: |
Human thyroid cancer and Human tonsil |
|
IHC Recommend dilution: |
25-100 |

 購物車
購物車 幫助
幫助
 021-54845833/15800441009
021-54845833/15800441009